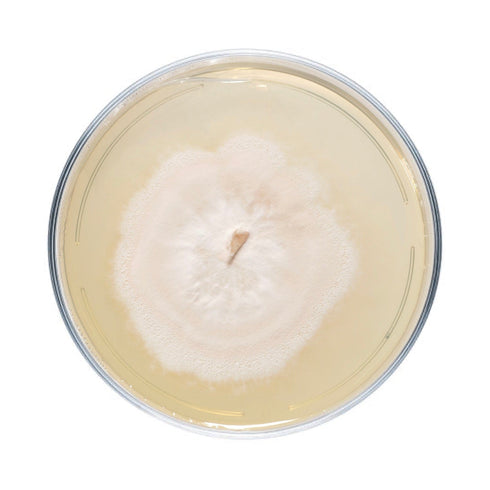

Species difficulty | Beginner |
Culture format | Agar plate |
Lab skills | Intermediate |
Shelf life | 6 months (refrigerated) |
Plate cultures are ideal for growers looking to make master bags, inoculate grain, make liquid culture, or make more plates.
Our wine cap plates are made to order in our in-house lab using medical-grade petri dishes. If properly stored upon arrival, they have a shelf life of approximately 6 months. Wine cap plates should be stored in the refrigerator to maintain viability. Note that mycelium cultures require basic lab skills. Handle using sterile technique to prevent contamination.
For complete descriptions of available wine cap strains, click on the names below.
-
Stropharia rugosoannulata. Cloned from a wine cap specimen that was naturalized on Winslow farm (an organic farm in Falmouth, Maine.) A prolific fruiter that tends to produce throughout the growing season. Can tolerate a wide variety of substrates.
-
Cloned from a wine cap specimen that was naturalized in Wisconsin.
-
Cloned from a wine cap specimen obtained from Radical Mycology Convergence.
-
Cloned from a wine cap specimen obtained from Mausum Valley Mushrooms.
You may also like
Making the world of mushrooms accessible to all
North Spore was launched in 2014 by a mycologist, an organic farmer, and a photojournalist -- three college friends brought together through their shared love of the mycological world.
What began as a simple love for mushroom foraging and cultivation quickly developed into an obsession with all things fungi. From there, an urban mushroom farm was born, as was the desire to spread the spore to the masses.